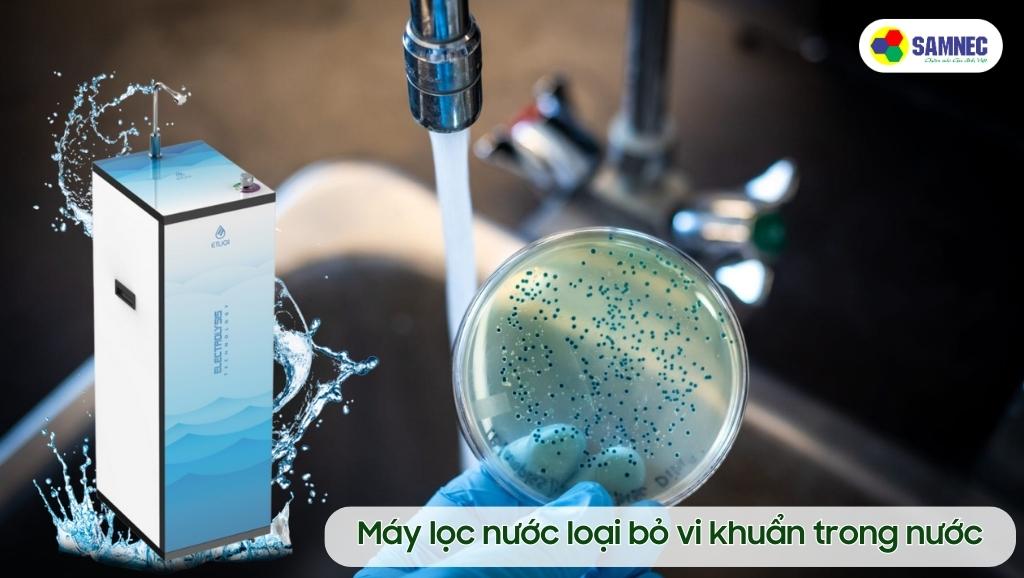
Máy lọc nước loại bỏ vi khuẩn trong nước

TOP 5 máy lọc nước được tin tưởng tại Điện máy SAMNEC
Đăng bởi: Grey Creative
Nước - nguồn tài nguyên quý báu, là yếu tố cơ bản duy trì cuộc sống. Trong một con người, 70% cơ thể chính là nước. Điều này chứng tỏ tầm quan trọng của nước đối với sức khỏe và sự sống. Tuy nhiên, nước không phải lúc nào cũng sạch và an toàn nên đây là lý do tại sao máy lọc nước trở nên cần thiết.
Trong bài viết này, hãy cùng SAMNEC khám phá tầm quan trọng của máy lọc nước và một số thương hiệu nổi tiếng cũng như các sản phẩm đang được bán chạy tại cửa hàng của chúng tôi.

I. Tầm quan trọng của việc sử dụng máy lọc nước
Tại sao lại cần máy lọc nước? Câu trả lời chính là đảm bảo nước sạch và an toàn. Nước không chỉ chiếm 70% cơ thể chúng ta mà còn là nguồn cung cấp khoáng chất quan trọng cho cơ thể. Tuy nhiên nước cũng có thể ẩn chứa vi khuẩn, hợp chất độc hại và tạp chất gây hại cho cơ thế. Dưới đây là một số lý do tại sao bạn nên sở hữu một chiếc máy lọc nước:
-
Nước là yếu tố cơ bản của cuộc sống: 70% cơ thể con người là nước. Điều này thể hiện rõ tầm quan trọng của nước trong việc duy trì sự sống và hoạt động của cơ thể. Để cơ thể hoạt động một cách hiệu quả, chúng ta cần hấp thu lượng nước sạch và an toàn

-
Bảo vệ sức khỏe: Sử dụng máy lọc nước giúp loại bỏ tạp chất, vi khuẩn và hợp chất độc hại có trong nước, giúp ngăn ngừa nhiều loại bệnh nghiêm trọng như tiêu chảy, viêm ruột và ung thư
-
Tiết kiệm tiền và bảo vệ môi trường: Thay vì mua nước đóng chai hàng ngày, máy lọc nước giúp bạn tiết kiệm rất nhiều tiền vì có thể uống trực tiếp tại vòi. Ngoài ra việc sử dụng thiết bị này còn giúp giảm lượng rác thải nhựa do chai lọ, giúp bảo vệ môi trường tự nhiên khỏi ô nhiễm

Tham khảo thêm các sản phẩm máy lọc nước
Máy lọc nước Karofi Livotec 110
Máy lọc nước nóng lạnh Karofi Livotec 612
II. Các thương hiệu máy lọc nước nổi tiếng
Toshiba đã trở thành một biểu tượng của chất lượng và đáng tin cậy trong ngành công nghiệp điện tử. Thương hiệu Toshiba không chỉ nổi tiếng với các sản phẩm như điều hoà và tủ lạnh mà còn trong lĩnh vực máy lọc nước. Máy lọc nước Toshiba luôn được đánh giá cao về hiệu suất và khả năng loại bỏ các tạp chất có hại trong nước.

Tham khảo máy lọc nước Toshiba
Máy lọc nước Toshiba TWP-N1843SV(T)
Máy lọc nước Toshiba TWP-W1643SV(W)
2. Máy lọc nước KoriHome
Máy lọc nước KoriHome là sản phẩm phổ biến và được nhiều gia đình lựa chọn. Thiết bị của KoriHome thường có thiết kế nhỏ gọn và dễ lắp đặt, phù hợp cho cả căn hộ nhỏ và nhà riêng. Với khả năng loại bỏ tạp chất và vi khuẩn, KoriHome luôn đảm bảo mang lại nguồn nước sạch cho người sử dụng.

Tham khảo máy lọc nước KoriHome
Máy lọc nước Korihome WPKG61K
Karofi là một tên tuổi đáng tin cậy trong lĩnh vực máy lọc nước. Sản phẩm của Karofi thường được trang bị các bộ lọc cao cấp để loại bỏ các chất độc hại và tạo ra nước có hương vị ngon hơn. Đặc biệt, máy lọc nước Karofi còn được thiết kế hiện đại, phù hợp với nhiều không gian nội thất.

Tham khảo máy lọc nước Karofi
Máy lọc nước nóng lạnh Karofi KAD-M28
Máy lọc nước nóng lạnh Karofi KAD-D66
Máy lọc nước Nagakawa là một thương hiệu uy tín và được nhiều người tin dùng. Sản phẩm của Nagakawa thường được tích hợp công nghệ tiên tiến để loại bỏ hiệu quả các tạp chất trong nước, đồng thời giữ lại các khoáng chất quan trọng cho sức khỏe. Điều này giúp cho nước không chỉ sạch mà còn bổ dưỡng.

Xem thêm: Tìm hiểu về máy lọc nước RO
Tham khảo máy lọc nước Nagakawa
Máy lọc nước Nagakawa NAG0503
Máy lọc nước Nagakawa NAG0504
III. Top 5 máy lọc nước được mua nhiều nhất tại Điện Máy SAMNEC
Sau đây là top 5 máy lọc nước được ưa chuộng nhất tại Điện máy SAMNEC
Máy lọc nước Karofi KTK8l1 là một trong những sản phẩm đang được ưa chuộng nhất tại SAMNEC. Được trang bị hệ thống 8 lõi lọc nước hiện đại giúp loại bỏ hoàn toàn chì và các chất độc hại ra khỏi nguồn nước, từ đó ngăn chúng xâm nhập vào cơ thể người dùng. Với Karofi KTK8I1, bạn hoàn toàn có thể thoải mái uống trực tiếp từ vòi nước mà không phải đun sôi, giảm thiểu thời gian chờ đợi và lượng điện tiêu thụ thêm trong quá trình đun nước.

Tham khảo sản phẩm máy lọc nước Karofi KTK8I1
Máy lọc nước Karofi KTK8I1
Máy lọc nước Karofi Optimus O-S129 có thiết kế được xem là nhỏ gọn nhất thị trường hiện nay, điều này không chỉ giúp tối ưu diện tích mà còn tạo nên điểm nhấn cho toàn bộ không gian căn phòng. Ngoài ra sản phẩm này sở hữu tới 9 lõi lọc nước và được chứng nhận về khả năng làm sạch nguồn nước theo quy chuẩn của Bộ Y Tế.

Tham khảo sản phẩm máy lọc nước Karofi Optimus O-S129
Máy lọc nước Karofi Optimus O-S129
Máy lọc nước Toshiba TWP-W1643SV(W) có khả năng lọc với công suất 7,8 lít nước/giờ, bình chứa nước có dung tích tới 4,6 lít tiện lợi cho mọi gia đình. Ngoài ra, sản phẩm này được trang bị hệ thống 4 lõi lọc, giúp loại bỏ hiệu quả tới 99,9% tạp chất và vi khuẩn, mang đến nguồn nước tinh khiết cho người dùng.

Tham khảo sản phẩm máy lọc nước Toshiba TWP-W1643SV(W)
Máy lọc nước Toshiba TWP-W1643SV(W)
Nagakawa NAG0504 là một trong những lựa chọn hàng đầu cho những người quan tâm đến sức khỏe và chất lượng nước. Máy lọc nước này được trang bị công nghệ lọc nước RO cao cấp có khả năng loại bỏ mọi loại tạp chất và vi khuẩn độc hại. Ngoài ra, hệ thống này còn bổ sung một số khoáng chất có lợi cho sức khỏe người dùng vào trong nguồn nước lọc. Bên cạnh đó máy lọc nước Nagakawa NAG0504 còn được tích hợp nhiều tính năng hiện đại như khả năng đun nước trực tiếp và giữ ấm trực tiếp hiện đại, tiện lợi cho người dùng.

Tham khảo sản phẩm máy lọc nước Nagakawa NAG0504
Máy lọc nước Nagakawa NAG0504
Korihome WPKG61K là một sản phẩm đa năng có khả năng loại bỏ các tạp chất, vi khuẩn và kháng khuẩn nước. Với thiết kế hiện đại và tiện lợi, nó phù hợp cho mọi gia đình. Hệ thống lọc nước với 10 lõi được nhập khẩu từ Hàn Quốc loại bỏ hoàn toàn cặn bẩn, vi khuẩn,... giúp bạn luôn có nguồn nước sạch sẽ và an toàn. Ngoài ra bộ lọc được thiết kế sao cho người dùng có thể dễ dàng thay mới sau một khoảng thời gian nhất định, tiết kiệm rất nhiều tiền khách hàng.

Tham khảo sản phẩm máy lọc nước Korihome WPKG61K
Máy lọc nước Korihome WPKG61K
Trong cuộc sống hiện đại, việc đảm bảo nguồn nước sạch là một trong những ưu tiên quan trọng nhất của con người. Với sự đa dạng về thương hiệu và sản phẩm máy lọc nước trên thị trường, bạn có nhiều lựa chọn để đảm bảo rằng nguồn nước mình uống hàng ngày là nước an toàn và tinh khiết. Hãy cân nhắc lựa chọn một trong những thương hiệu và sản phẩm được đề xuất ở trên để bảo vệ sức khỏe bản thân và gia đình mình.
Nếu bạn đang có mua cầu muốn mua các sản phẩm máy lọc nước, hãy ghé qua các cửa hàng Điện máy SAMNEC của chúng tôi để nhận được những tư vấn và ưu đãi tốt nhất.











